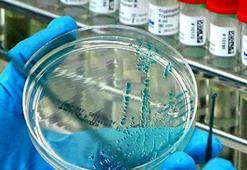
‘Yeni pandemi kapıyı çalıyor’

İtlaf
Son dakika itlaf haberleri ile ilgili Milliyet'e eklenen tüm haberler bu sayfada yer almaktadır. Geçmişte yaşanan itlaf gelişmeleri, bugün yaşanan en flaş gelişmeler ve çok daha fazlası sürekli güncel olan itlaf haber sayfamızda...
İtlaf
haber başlıkları altta listelenmiştir. Son dakika haberleri de dahil olmak üzere şu ana kadar eklenen toplam 622 itlaf haberi bulunmuştur.
Aslanın kaçtığı hayvanat bahçesi ile ilgili flaş gelişmeAntalya'nın Manavgat ilçesinde bir çiftçiye tarlada saldırdıktan sonra ormanlık alanda itlaf edilen aslanın kaçtığı hayvanat bahçesi, yapılacak denetim sonuna zabıta ekiplerince mühürlendi.
7.07.2025Gündem

Antalya'da aslan saldırısı! Kafesinden kaçtı, bir kişiyi ağır yaraladıAntalya’nın Manavgat ilçesinde akıllara durgunluk veren bir olay yaşandı. Hayvan parkındaki kafesinden kaçan aslan, Süleyman Kır'a (53) saldırdı ve ağır yaraladı. Olay sonrası ormana kaçan aslandan haber geldi.
6.07.2025Gündem

Civciv baronları yakalandı! İsyanı şaşkına çevirdiAydın'ın İncirliova ilçesinde sertifikasız ve sağlıksız şartlarda 5 bine yakın kanatlı hayvan üretiminin yapıldığı çiftlikteki itlaf işlemleri sırasında ekiplere zorluk çıkartan biri kadın 5 şüpheli gözaltına alındı. Şüphelilerden biri adliyeye sevkleri sırasında yaşananlara serzenişte bulundu.
18.04.2025Gündem

İngiltere'de ilk kez bir koyunda kuş gribi tespit edildiİngiltere'de kzulama dönemi devam ederken, Yorkshire'daki bir çiftlikte bir koyunda virüs bulundu. İşte kuş gribi vakası ve kuş gribi hakkında bilmeniz gerekenler...
24.03.2025Dünya

Sahipli köpek kuduz çıktı! Bölge 6 ay karantinaya alındıAdıyaman'ın Besni ilçesi Köseceli beldesinde sahipli bir köpeğin kuduz olduğunun anlaşılması üzerine belde karantinaya alındı.
12.03.2025Gündem

ABD’de yumurta AB’de tereyağı kriziİklim krizi başta olmak üzere su kısıtı ve hastalık riskleri dünyada gıda güvenliğini tehdit etmeye devam ediyor. ABD’de kuş gribi ardından yumurta; AB’de ise tereyağı fiyatlarında tarihi seviyeler görüldü. Enerji sorunu ve tüketici talebi de gıdanın geleceği üzerinde önemli bir etken haline geldi.
26.02.2025Ekonomi

ABD'deki kuş gribi krizi Türk yumurtasına talebi artırdıYumurta Üreticileri Merkez Birliği (YUM-BİR) Başkanı İbrahim Afyon, geçen yıl deneme alımları yapan ABD ile haziran ayına kadar çıkışı yapılacak yaklaşık 15 bin ton yumurta talebi için ön anlaşma yapıldığını belirterek, "ABD, çok süreceğini tahmin etmediğimiz kuş gribi salgını geçene kadar ihtiyacını güvenli ve tedarik gücü yüksek olan Türkiye'den sağlayacak." dedi.
14.02.2025Ekonomi

Almanya'da 35 yıl sonra görülen şap hastalığı paniği!Almanya'nın Brandenburg eyaletinde bir manda sürüsünde şap hastalığının tespit edilmesinin ardından Berlin'deki hayvanat bahçesi, hayvan parkı ve çocuk çiftlikleri, şap hastalığı nedeniyle kapatıldı. İşte detaylar...
12.01.2025Dünya
‘Yeni pandemi kapıyı çalıyor’ABD’de inekler arasında yayılıp insanlara bulaşan kuş gribi virüsü H5N1 mutasyona uğrama belirtileri gösteriyor. Uzmanlar, “Kuş gribi kapımızı çalıyor, her an yeni bir pandemi patlayabilir” dedi.
12.12.2024Dünya

Eskişehir'de kuş gribi alarmı! 5 mahalle karantinaya alındıEskişehir’in Sivrihisar ilçesinde ortaya çıkan kuş gribi hastalığı sebebi ile 204 kanatlı hayvan itlaf edilirken karantina altına alınan mahalledeki tedbir ve çalışmalar titizlikle sürüyor.
11.11.2024Gündem

Barınakta 17 kedi ve köpek öldü! Adli ve idari soruşturma başlatıldıKırklareli Belediyesi Geçici Hayvan Bakımevi'nde, 8 köpek ve 9 kedi olmak üzere 17 hayvan öldü. Kırklareli Belediye Başkanı Derya Bulut, hayvanların hastalıklara bağlı olarak öldüğünü belirterek, "Adli makamlar zaten gerekli soruşturmayı başlattı" dedi.
16.10.2024Gündem

CHP lideri Özel: Savaş çıkarsa bu memleketi biz koruruzCumhuriyet Halk Partisi (CHP) Genel Başkanı Özgür Özel, "Biz mücadele edenlerin kazandığını, başardığını tüm Türkiye'ye gösterdik. Bundan sonra da hep birlikte mücadele ederek başaracağız ve Türkiye'de iktidar olacağız" dedi.
12.10.2024Gündem

Gebze'deki hayvan ölümleri! Belediye başkanı: Herkese hesabını soracağızKocaeli'nin Gebze ilçesinde belediyeye ait Sokak Hayvanları Rehabilitasyon Merkezi'nde dün 45 hayvanın ölü bulunmasına ilişkin Gebze Belediye Başkanı Zinnur Büyükgöz, "Sürecin başından sonuna kadar kurum içinde ya da dışarıda hepimizi derinden sarsan bu görüntülere sebep olan herkese hesabını soracağız" dedi.
12.10.2024Gündem

AK Parti Genel Başkan Yardımcısı Hamza Dağ'dan Paris göndermesiAK Parti Genel Başkan Yardımcısı Hamza Dağ, "Bazıları gibi ortalık yangın yeriyken tatil yapmıyoruz. Bir hafta Roma'ya, bir hafta Paris'e, bir hafta da Almanya'ya gidip Avrupa Şampiyonası maçlarında vakit geçirip günümüzü gün etmiyoruz. Biz siyasetin ciddi bir iş olduğunu onlar gibi laçkalaşmış ve kokuşmuş ilişkiler içinde olmayacağını gayet iyi biliyoruz." açıklamasında bulundu.
11.08.2024Gündem

Finlandiya'dan dünyada bir ilk: İnsanlara kuş gribi aşısı yapılacakFinlandiya dünyada bir ilke imza atarak, işleri ya da diğer koşullar nedeniyle kuş gribine yakalanma riski yüksek kişilere için gelecek haftadan itibaren aşılama yapmaya başlayacak.
27.06.2024Dünya

İBB Meclisi'nde sokak köpekleri tartışması! 'Dünyaya örnek olabilecek şekilde çözebiliriz'İstanbul Büyükşehir Belediye (İBB) Meclisi Haziran ayı ikinci oturumunda, sahipsiz köpekler gündeme alındı.
11.06.2024Gündem

Erdoğan’dan yasal düzenleme uyarısı: Tedbir alalım ama ölçüyü koruyalımAK Parti, sahipsiz sokak hayvanlarıyla ilgli 8 maddelik yasa taslağını tamamladı. Taslak önümüzdeki hafta Cumhurbaşkanı Recep Tayyip Erdoğan’a sunulacak ardından da metin olarak muhalefete götürülecek.
29.05.2024Gündem

CHP'li Özel'den sokak köpekleri açıklamasıTürkiye'de başıboş sokak köpekleri sorunu olduğunu söyleyen CHP Genel Başkanı Özgür Özel, "Bu sorun özellikle sabahın erken saatlerinde okula yaya gitmek zorunda olan çocukların, gençlerin; bu sorun servise gitmek isteyen emekçilerin, camiye giden yaşlıların bir güvenlik sorunu haline dönüşmüştür." dedi.
28.05.2024Gündem

‘Köpekleri uyutmada uzlaşmayız’CHP Genel Başkanı Özgür Özel, dün bir televizyonda katıldığı canlı yayında soruları yanıtladı.
25.05.2024Gündem

Sokak köpeği sorunu nasıl çözülecek?AK Parti hükümeti başıboş sokak hayvanlarıyla ilgili yasal düzenleme başlatırken, ‘30 gün içerisinde sahiplenilmeyen sokak köpeklerinin iğne ile uyutulması’ önerisi tartışma yarattı.
24.05.2024Gündem

Sokak köpeklerine çözüm tartışılıyor! İğneyle ‘uyutma’ tepki topladıSokak hayvanlarına ilişkin düzenleme kapsamında, 30 gün içerisinde sahiplenilmeyen köpeklerin iğneyle “uyutulması” önerisi tepki toplandı. Hayvan hakları savunucuları ve muhalefet, teklife karşı çıkarken kısırlaştırma önerisinde bulundu.
23.05.2024Gündem

'Sokaklarımızın saldırgan köpeklerden temizlenmesini bekliyoruz'Büyük Birlik Partisi Genel Başkanı Mustafa Destici, sokak hayvanlarına yönelik hazırlanan kanun teklifinde yer alan maddelerin partisinin önerdiği taslak metinde de olduğunu söyleyerek, “Bunu destekliyoruz ve süratli bir şekilde meclise gönderilmesini ve bu dönem meclis kapanmadan da mutlaka bu kanunun yasalaşarak çıkmasını ve artık sokaklarımızın bu saldırgan köpeklerden temizlenmesini bekliyoruz” şeklinde konuştu.
22.05.2024Gündem

ABD’de kuş gribi alarmıABD’de geçtiğimiz günlerde Teksas ve Kansas’taki çiftliklerde ineklerde ve sütlerinde ilk kez kuş gribi (H5N1) tespit edildi.
5.04.2024Dünya

Patili dostlarımızın hakları ve yaşadıkları31 Mart 2024’te gerçekleşecek yerel seçimlerde adayların başta sokak hayvanları olmak üzere patili dostlarımız konusundaki projelerinin oyları etkileyeceği konuşuluyor. İBB tarafından hazırlanan “Hayvan Hakları ve Türkiye” adlı kitap bir yol haritası olarak işin uzmanlarının yazılarını bir araya getiriyor.
11.02.2024Kültür Sanat

Aniden bulanık suda belirdi, dişlerini kafatasına geçirdi! Köpekbalığı dişleri koleksiyoncusu olan genç adam, yaşamak üzere olduğu korkunç saldırıdan habersiz dalış yaptığı nehrin tadını çıkarıyordu. Birdenbire dayanılmaz bir acı hissetti, ilk şokun etkisiyle, bir teknenin başına çarptığını sandı. Ta ki, vahşi timsahın dişlerini kafatasına geçirdiğini fark ettiği ana kadar...
16.01.2024Dünya